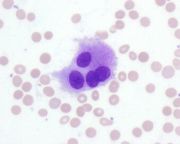

由Admin上传
来自医学百科
本特殊页面展示所有上传的文件。
| 日期 | 名称 | 缩略图 | 尺寸 | 说明 | 版本 |
|---|---|---|---|---|---|
| 2014年3月17日 (一) 14:21 | Bkaah.jpg (文件) |  |
165 KB | 1 | |
| 2014年3月17日 (一) 14:20 | Bklwl.jpg (文件) |  |
73 KB | 1 | |
| 2014年3月17日 (一) 14:20 | Bkefs.jpg (文件) |  |
27 KB | 1 | |
| 2014年3月17日 (一) 14:20 | Bk8ze.jpg (文件) |  |
38 KB | 1 | |
| 2014年3月17日 (一) 14:20 | Bkkb9.jpg (文件) |  |
46 KB | 1 | |
| 2014年3月17日 (一) 14:20 | Bkqh1.jpg (文件) |  |
55 KB | 1 | |
| 2014年3月17日 (一) 14:20 | Bkp3s.jpg (文件) |  |
48 KB | 1 | |
| 2014年3月17日 (一) 14:20 | Bkat7.jpg (文件) |  |
41 KB | 1 | |
| 2014年3月17日 (一) 14:19 | Bkb9y.jpg (文件) |  |
45 KB | 1 | |
| 2014年3月17日 (一) 14:19 | Bkkyg.jpg (文件) |  |
15 KB | 1 | |
| 2014年3月17日 (一) 14:19 | Bke1g.jpg (文件) |  |
56 KB | 1 | |
| 2014年3月17日 (一) 14:19 | Bkj8z.jpg (文件) |  |
11 KB | 1 | |
| 2014年3月17日 (一) 14:18 | Bko6f.jpg (文件) |  |
13 KB | 1 | |
| 2014年3月17日 (一) 14:18 | Bk971.jpg (文件) |  |
31 KB | 1 | |
| 2014年3月17日 (一) 14:18 | Bk9tt.jpg (文件) |  |
131 KB | 1 | |
| 2014年3月17日 (一) 14:18 | Bk5zc.jpg (文件) |  |
272 KB | 1 | |
| 2014年3月17日 (一) 14:18 | Bk0de.jpg (文件) |  |
18 KB | 1 | |
| 2014年3月17日 (一) 14:17 | Bk6vr.jpg (文件) |  |
50 KB | 1 | |
| 2014年3月17日 (一) 14:17 | Bk7bd.jpg (文件) |  |
421 KB | 1 | |
| 2014年3月17日 (一) 14:17 | Bkf0g.jpg (文件) |  |
262 KB | 1 | |
| 2014年3月17日 (一) 14:17 | 流式细胞术原理.gif (文件) | 生成缩略图出错:无法找到文件 |
105 KB | 2 | |
| 2014年3月17日 (一) 14:17 | Bk8b8.jpg (文件) |  |
74 KB | 1 | |
| 2014年3月17日 (一) 14:17 | Bk95o.jpg (文件) |  |
196 KB | 1 | |
| 2014年3月17日 (一) 14:16 | Bk7li.jpg (文件) |  |
48 KB | 1 | |
| 2014年3月17日 (一) 14:16 | Bkm9r.jpg (文件) |  |
39 KB | 1 | |
| 2014年3月17日 (一) 14:16 | Bkljj.jpg (文件) |  |
43 KB | 1 | |
| 2014年3月17日 (一) 14:16 | Bkpun.jpg (文件) |  |
450 KB | 1 | |
| 2014年3月17日 (一) 14:16 | Bkl1b.jpg (文件) |  |
53 KB | 1 | |
| 2014年3月17日 (一) 14:15 | Bkair.jpg (文件) |  |
29 KB | 1 | |
| 2014年3月17日 (一) 14:15 | Gktm8f4z.jpg (文件) |  |
2 KB | 1 | |
| 2014年3月17日 (一) 14:15 | Bkagt.jpg (文件) |  |
43 KB | 1 | |
| 2014年3月17日 (一) 14:15 | Bk7dh.jpg (文件) |  |
51 KB | 1 | |
| 2014年3月17日 (一) 14:15 | Bk7xg.jpg (文件) |  |
93 KB | 1 | |
| 2014年3月17日 (一) 14:15 | 二期梅毒疹-手掌.jpg (文件) | 生成缩略图出错:无法找到文件 |
30 KB | 2 | |
| 2014年3月17日 (一) 14:15 | Bk1nl.jpg (文件) |  |
42 KB | 1 | |
| 2014年3月17日 (一) 14:14 | Bkan2.jpg (文件) |  |
32 KB | 1 | |
| 2014年3月17日 (一) 14:14 | Bka0s.jpg (文件) |  |
42 KB | 1 | |
| 2014年3月17日 (一) 14:14 | Bkojc.jpg (文件) |  |
84 KB | 1 | |
| 2014年3月17日 (一) 14:14 | Bk6vj.jpg (文件) |  |
75 KB | 1 | |
| 2014年3月17日 (一) 14:14 | Bklw8.jpg (文件) |  |
70 KB | 1 | |
| 2014年3月17日 (一) 14:10 | Bkd9k.jpg (文件) |  |
50 KB | 1 | |
| 2014年3月17日 (一) 14:10 | Bkai5.jpg (文件) |  |
77 KB | 1 | |
| 2014年3月17日 (一) 14:10 | Bkl2l.jpg (文件) |  |
33 KB | 1 | |
| 2014年3月17日 (一) 14:09 | Bkbb6.jpg (文件) |  |
3 KB | 1 | |
| 2014年3月17日 (一) 14:09 | Bk3yu.jpg (文件) |  |
81 KB | 1 | |
| 2014年3月17日 (一) 14:09 | Bk2uk.jpg (文件) | 10 KB | 1 | ||
| 2014年3月17日 (一) 14:09 | Bkatj.jpg (文件) | |
117 KB | 1 | |
| 2014年3月17日 (一) 14:08 | Bk7hl.jpg (文件) |  |
125 KB | 1 | |
| 2014年3月17日 (一) 14:08 | Bk4t9.jpg (文件) |  |
12 KB | 1 | |
| 2014年3月17日 (一) 14:08 | Bkkg4.jpg (文件) |  |
14 KB | 1 |